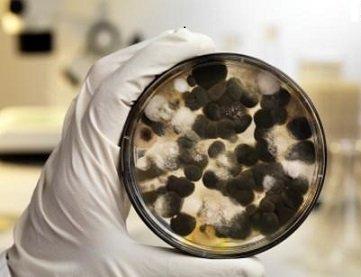
In SE Texas mold is a year round issue.

American Language Services
Advertisement
American Language Services, founded in 1985, is a premier language service provider specializing in translations, interpreting, and media services across a diverse range of industries. With offices strategically located in major cities such as Los Angeles, New York, and Houston, the company is dedicated to delivering high-quality, timely solutions that connect clients with top linguists worldwide.
Recognized for its commitment to quality and customer satisfaction, American Language Services holds ISO 9001 and 13485 certifications and employs advanced technology to ensure secure and efficient service delivery. Their extensive portfolio includes legal, medical, corporate, and entertainment sectors, reflecting their adaptability and expertise in meeting the language needs of their clientele.
Generated from the website
Also at this address
You might also like
Advertisement